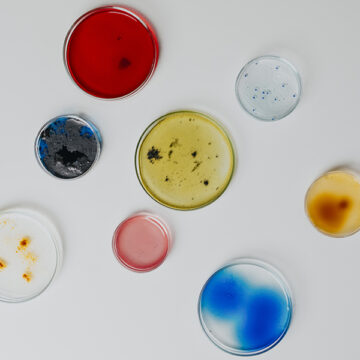
Robot e batteri salvano le opere d’arte

Robot e batteri salvano le opere d’arte
Letizia Palmisano
Dal bio-restauro alle tecniche più innovative, l’Italia è in prima fila nello studio del restauro e dei materiali di conservazione.